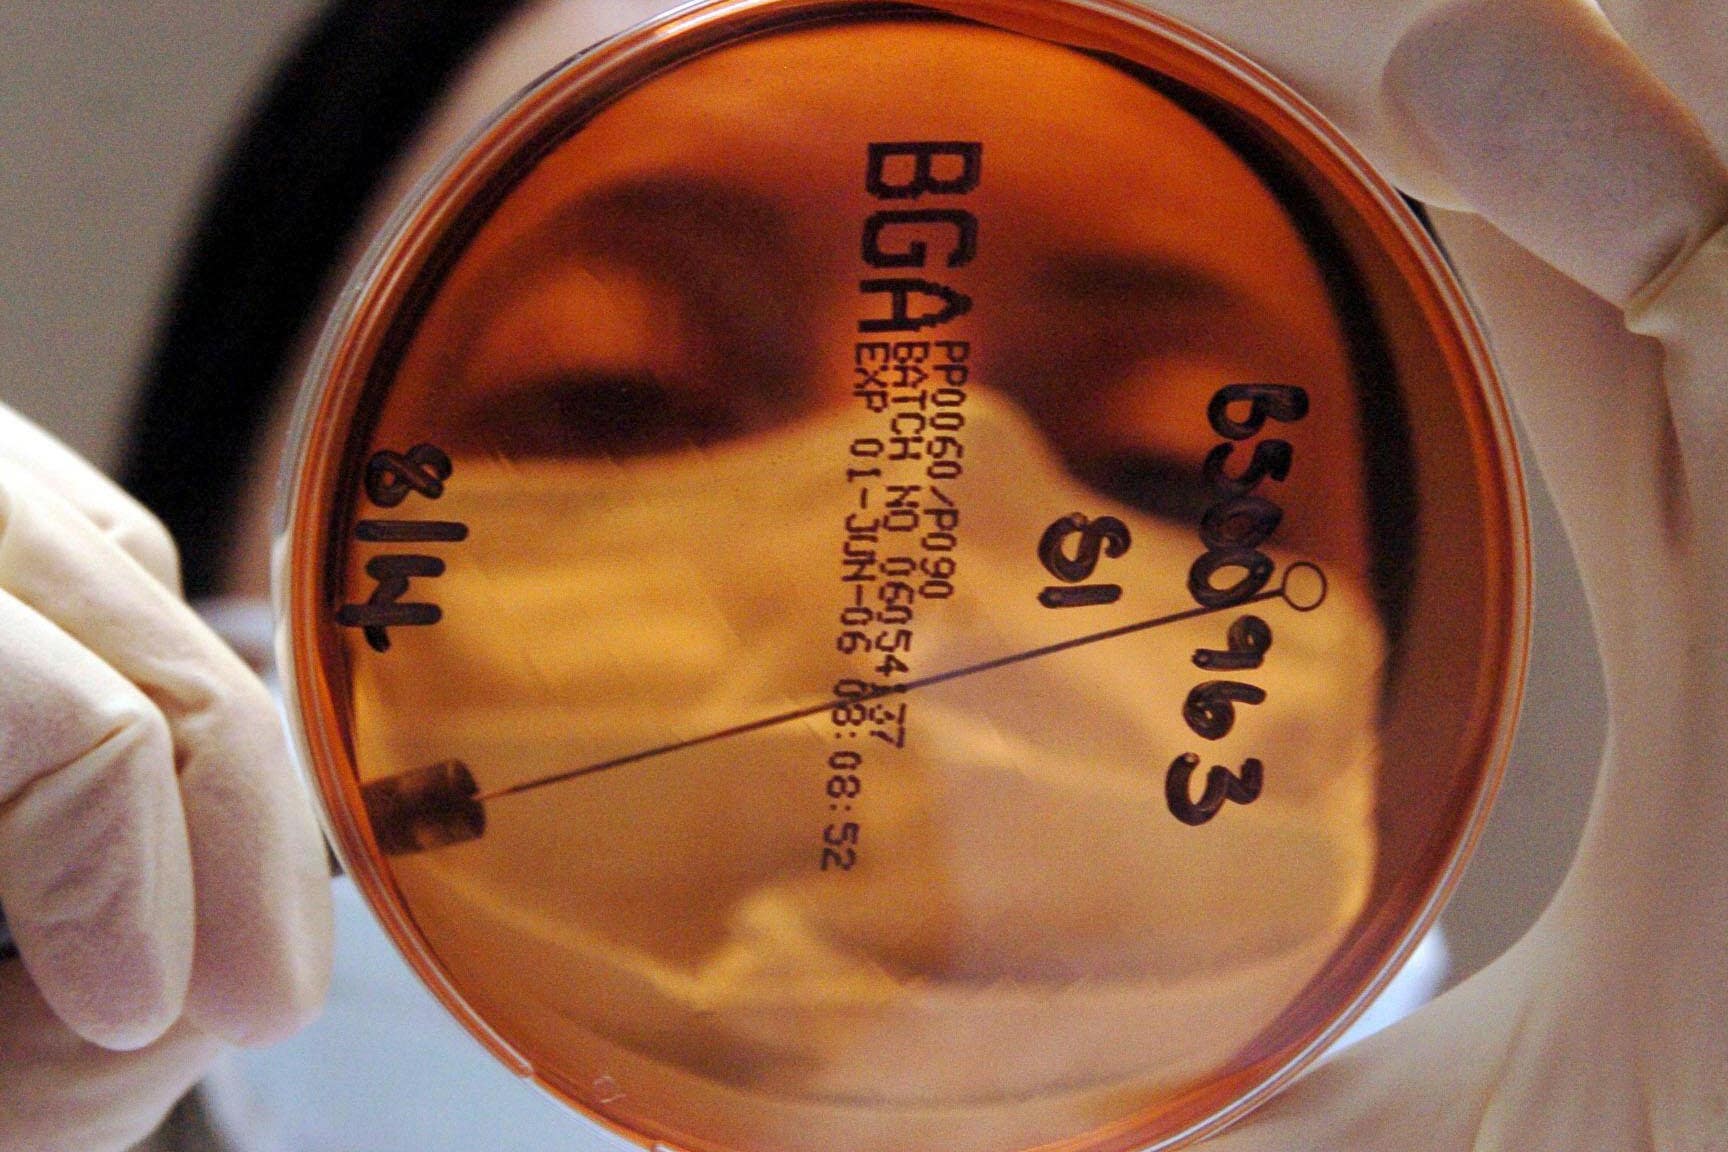

Вы хотите купить iPhone в Уфе? Мы предлагаем новейшие модели, в том числе iPhone 17 в Уфе, iPhone 16 в Уфе, iPhone 15 в Уфе и другие. У нас можно купить айфон уфа с доставкой и гарантией.
Особое внимание уделяем моделям iPhone 17: iPhone 17 Pro купить в Уфе, iPhone 17 Pro Max купить уфа, iPhone 17 Air купить уфа. Также у нас доступны iPhone 17 в Уфе, iPhone 17 Pro Max купить айфон уфа про макс уфа, и iPhone 17 512 уфа — все по выгодным ценам.
Для поклонников более ранних моделей у нас есть iPhone 16 купить в Уфе и iPhone 15 купить в Уфе. Вы можете выбрать купить iPhone 16 уфа или iPhone 15 уфа — все модели в наличии.
Для поклонников более ранних моделей у нас есть iPhone 16 купить в Уфе и iPhone 15 купить в Уфе. Вы можете выбрать купить iPhone 16 уфа или iPhone 15 уфа — все модели в наличии.
